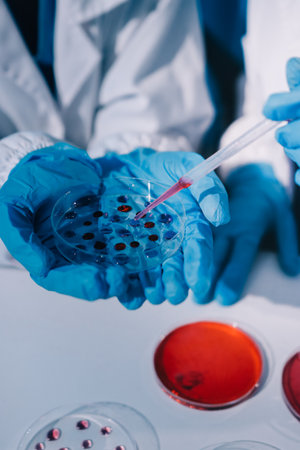
Researcher using a professional microscopeの写真素材

写真素材 - Researcher using a professional microscope
キーワード
- adult
- analyzing
- biochemistry
- biology
- biotechnology
- blue
- chemical
- chemist
- chemistry
- close-up
- concentration
- copy space
- development
- discovery
- dna
- doctor
- education
- equipment
- examining
- expertise
- healthcare and medicine
- hospital
- industry
- innovation
- laboratory
- liquid
- looking
- medical equipment
- medical test
- medicine
- microbiology
- microscope
- one person
- one woman only
- pharmacy
- pipette
- professional occupation
- research
- science
- scientist
- technician
- technology
- test tube
- tube
- water
- working
- young adult
- young women
類似作品
Laboratory assi...
Gaining a deepe...
Side close up v...
young scientist...
Laboratory Rese...
Close up view o...
Close up view o...
Woman chemist i...
female laborato...
Closeup scienti...
Laboratory Rese...
Scientist in bl...
Laboratory assi...
Microscope sett...
Close up view o...
laboratory assi...
Modern microsco...
Scientist using...
Laboratory assi...
close up resear...
microscope rese...
close up. scien...
image of young ...
Close up view o...
Scientist analy...
A western scien...
Abstract Motion...
Scientist using...
A man at the mi...
A young men sci...
Close-up shot o...
Women work in t...
Asian male rese...
young scientist...
Laboratory assi...
Laboratory Rese...
Macro Close Up ...
woman in labora...
woman laborator...
Scientist condu...
Woman scientist...
image of a scie...
Young pretty do...
Woman in white ...
Close up of Sci...
Female Medical ...
female laborato...
Young scientist...
Experiment scie...